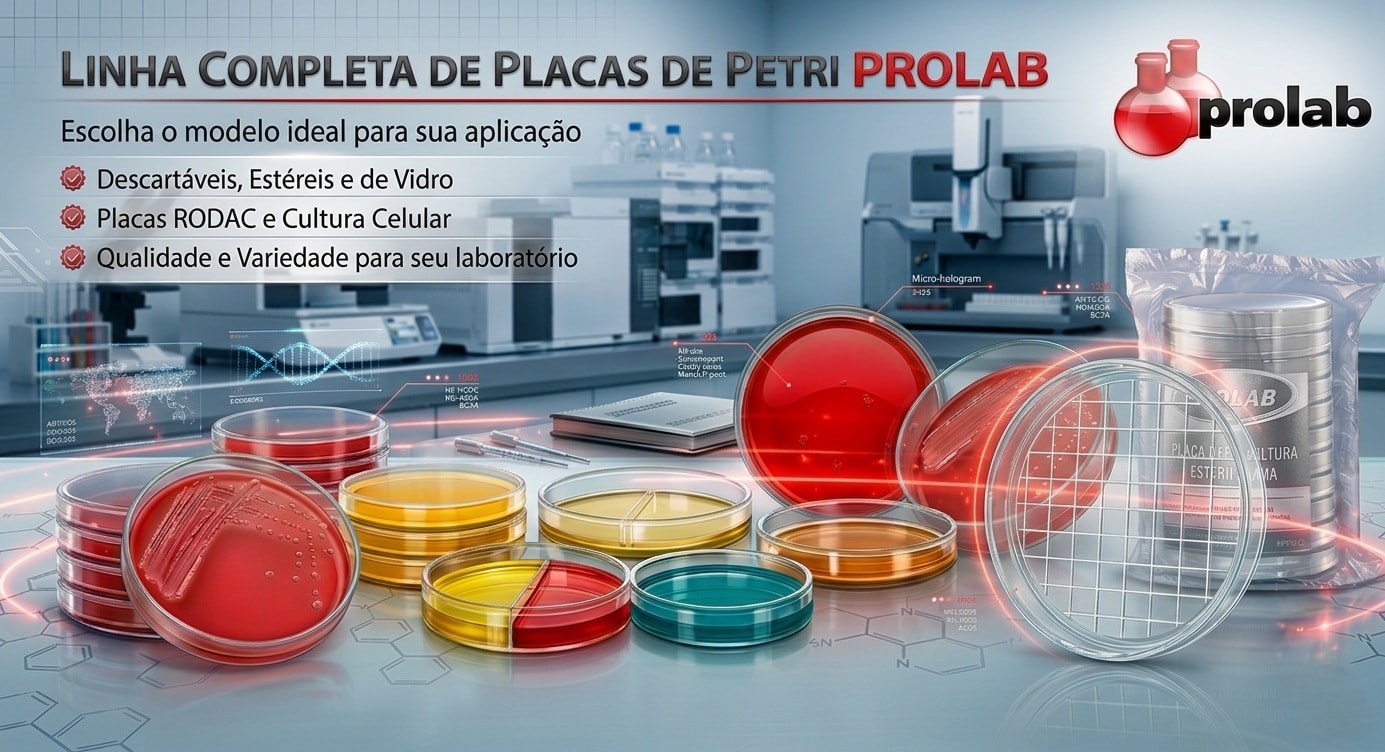
Linha completa de placas de petri Prolab

Placa de Petri
Placa De Petri 90x15mm Descartável Estéril Com 2 Compartimentos Caixa Com 300 Unidades
R$ 334,67 no Pix
ou R$ 345,02 em até em até 6x de R$ 57,50 sem juros no cartão
Placa De Petri 90x15mm Descartável Estéril Com 3 Compartimentos Caixa Com 300 Unidades
R$ 369,96 no Pix
ou R$ 381,40 em até em até 7x de R$ 54,49 sem juros no cartão
Placa de Petri Descartável Estéril
R$ 11,00 no Pix
R$ 11,00 no boleto
Placa de Petri Para Cultura Celular 135,5mm Kasvi 5 Unidades
R$ 60,12 no Pix
R$ 60,12 no boleto
Placa de Petri Para Cultura Celular 52mm Kasvi 10 Unidades
R$ 24,37 no Pix
R$ 24,37 no boleto
Placa de Rodac 65x10mm Pacote com 10 Unidades
R$ 9,03 no Pix
R$ 9,03 no boleto
Placa de Petri para laboratório: estéril, descartável, RODAC, cultura celular e vidro
Encontre na Prolab a placa de petri ideal para microbiologia, cultivo de microrganismos, cultura celular, controle ambiental, ensino, pesquisa e controle de qualidade. Trabalhamos com placa de petri plástica descartável, placa de petri estéril, placa RODAC, placa de petri com divisórias e placa de petri de vidro, com opções para diferentes protocolos laboratoriais.
Qual placa de petri escolher?
Descartável estéril: microbiologia e rotina controlada.
RODAC: controle ambiental e superfícies.
Cultura celular: cultivo específico em laboratório.
Por que comprar na Prolab?
A Prolab oferece consumíveis para laboratório com foco em qualidade, variedade de modelos, excelente custo-benefício e atendimento especializado para diferentes aplicações.
Precisa de ajuda?
Nossa equipe pode indicar a placa de petri ideal conforme aplicação, diâmetro, esterilidade, material e tipo de cultura.
Falar com um EspecialistaQual placa de petri escolher? Veja o modelo ideal para sua rotina
Placa de Petri descartável estéril
Ideal para: microbiologia, cultivo de microrganismos, rotina laboratorial e análises com menor risco de contaminação.
- Prática e pronta para uso
- Boa visualização da cultura
- Indicada para uso único
- Excelente para rotina microbiológica
Placa RODAC e divisórias
Ideal para: controle ambiental, monitoramento de superfícies, amostragens específicas e separação de culturas.
- Indicada para controle higiênico
- Modelos específicos para protocolo
- Mais organização da amostra
- Boa escolha para controle de qualidade
Placa de Petri para cultura celular
Ideal para: aplicações específicas, protocolos laboratoriais mais exigentes e cultivos especializados.
- Opções para cultura celular
- Modelos reutilizáveis em vidro
- Mais adequação ao protocolo
- Linha mais técnica e específica
O que é uma placa de petri?
A placa de petri é um recipiente raso, circular e com tampa, amplamente utilizado em microbiologia, cultura celular, ensino, pesquisa e controle de qualidade. Ela permite o crescimento, observação e isolamento de microrganismos em meios de cultura sólidos ou líquidos, além de aplicações específicas em monitoramento ambiental e protocolos laboratoriais.
Em laboratório, a placa de petri é utilizada para cultivo de bactérias, fungos e outras análises que exigem visualização clara da amostra. Dependendo do protocolo, pode ser utilizada em versões descartáveis estéreis, de vidro, RODAC ou para cultura celular.
Por isso, escolher corretamente o tipo, o diâmetro, o material e o nível de esterilidade faz diferença direta no resultado da rotina laboratorial.
Placas de Petri mais vendidas e recomendadas
Placa de Petri 90x15mm Estéril
Tamanho clássico para microbiologia, rotina laboratorial e cultivo de microrganismos com excelente praticidade.
Placa de Petri com divisórias
Boa escolha para aplicações que exigem separação de áreas, organização da análise e rotina prática.
Placa para cultura celular e RODAC
Indicada para protocolos específicos, controle ambiental e aplicações laboratoriais mais especializadas.
Tipos de placa de petri disponíveis
Placa de Petri plástica descartável
Indicada para uso rotineiro em microbiologia, ensino e controle de qualidade, com praticidade, segurança e redução de risco de contaminação.
Placa de Petri estéril
Pronta para uso em análises microbiológicas e cultivos que exigem maior controle e menor interferência externa.
Placa de Petri de vidro
Opção reutilizável e tradicional, indicada para protocolos específicos e rotinas que utilizam esterilização e reaproveitamento do material.
Placa RODAC
Indicada para controle ambiental e monitoramento microbiológico de superfícies em laboratórios, indústrias e áreas controladas.
Placa para cultura celular
Desenvolvida para aplicações específicas em cultura celular, com opções técnicas voltadas para protocolos laboratoriais mais sensíveis.
Placa com divisórias
Útil para análises comparativas, divisão de amostras e protocolos que exigem separação física dentro da mesma placa.
Como escolher a placa de petri ideal?
1. Aplicação
Defina se o uso será em microbiologia, cultura celular, ensino, pesquisa, controle de qualidade ou controle ambiental.
2. Esterilidade
Para protocolos microbiológicos e análises críticas, placas estéreis costumam ser a escolha mais segura.
3. Material
Plástico descartável oferece praticidade. Vidro pode ser útil em rotinas específicas que exigem reutilização.
4. Diâmetro e formato
Escolha conforme o volume de meio, o protocolo utilizado e a necessidade de placa lisa, ventilada, RODAC ou com divisórias.
Qual placa de petri é melhor para cada rotina?
Principais aplicações da placa de petri
Placa de petri de plástico ou vidro: qual escolher?
A escolha entre placa de petri plástica e placa de petri de vidro depende do protocolo, da frequência de uso e da necessidade de reutilização. Modelos plásticos descartáveis costumam ser preferidos na rotina por praticidade, menor risco de contaminação cruzada e agilidade operacional.
Já a placa de petri de vidro pode ser útil em aplicações específicas, quando o laboratório trabalha com esterilização e reaproveitamento do material. O mais importante é alinhar o tipo de placa ao objetivo da análise e às exigências do procedimento.
Para microbiologia rotineira e uso frequente, placas descartáveis estéreis costumam ser a escolha mais prática. Para protocolos particulares, o vidro pode fazer sentido.
Perguntas frequentes sobre placa de petri
Para que serve a placa de petri?
A placa de petri serve para cultivo, observação e isolamento de microrganismos, além de aplicações em cultura celular, ensino, pesquisa e controle de qualidade.
Qual a diferença entre placa de petri estéril e não estéril?
A placa estéril já vem pronta para uso em microbiologia e protocolos controlados. A não estéril pode ser utilizada em aplicações gerais ou após esterilização adequada.
Placa de petri descartável é melhor?
Para a maioria das rotinas laboratoriais, a placa descartável oferece mais praticidade, segurança e agilidade, especialmente em análises microbiológicas frequentes.
Placa de petri de vidro ou plástico?
O plástico descartável é mais prático e amplamente usado na rotina. O vidro pode ser interessante em protocolos específicos que utilizam esterilização e reutilização do material.
Qual tamanho de placa de petri escolher?
O tamanho depende do volume de meio, do tipo de análise e do protocolo adotado. Modelos como 60 mm, 90 mm e 100 mm são comuns em diferentes rotinas laboratoriais.
O que é placa RODAC?
A placa RODAC é um modelo utilizado principalmente para controle ambiental e monitoramento microbiológico de superfícies.
Qual placa de petri escolher para microbiologia?
Em microbiologia, placas descartáveis estéreis costumam ser a escolha mais indicada por oferecerem praticidade, segurança e menor risco de contaminação.
Compre placa de petri na Prolab
A Prolab oferece soluções em placa de petri para diferentes níveis de exigência, desde rotinas básicas de ensino até protocolos microbiológicos, cultura celular e controle ambiental mais específicos. Se você procura placa de petri estéril, placa de petri descartável, placa RODAC ou modelos especiais para laboratório, explore os produtos disponíveis nesta categoria e escolha a opção ideal para sua rotina.
Trabalhamos com consumíveis para laboratório com foco em desempenho, confiabilidade, variedade de aplicações e suporte especializado.









